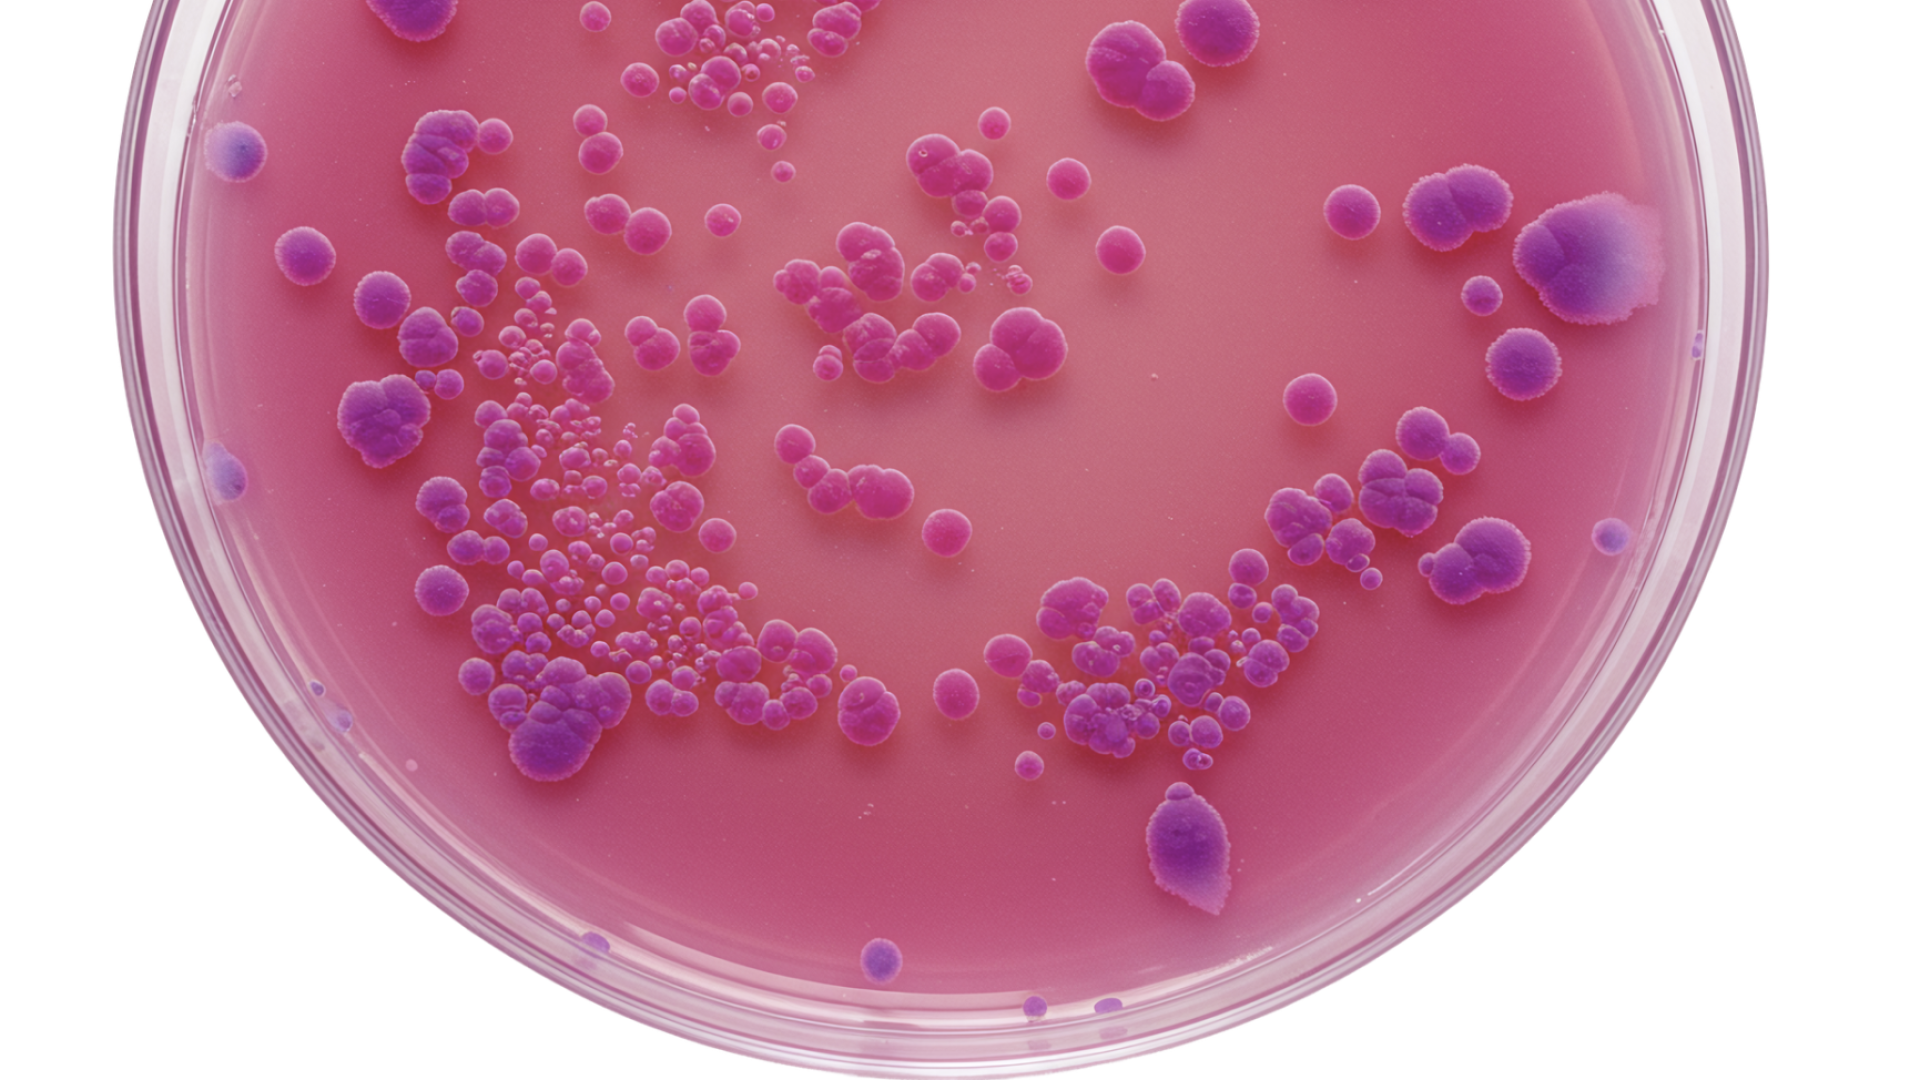
Telepszám 22 °C-on és 37 °C-on

A telepszám azt mutatja meg, mennyi baktérium képes elszaporodni a vízmintából meghatározott hőmérsékleten — 22 °C-on vagy **37 °C-on. Ez az érték nem közvetlenül az egészségügyi kockázatot méri, hanem a vízhálózat általános bakteriális állapotát és a baktériumok szaporodását elősegítő körülményeket jelzi.
2. 22 °C-on tenyésztett telepszám
A 22 °C-on növő baktériumok többnyire környezeti eredetű, emberre veszélytelen mikroorganizmusok, amelyek a hálózat állapotáról, a víz pangásáról, vagy a szervesanyag-tartalomról adnak képet. A magas érték arra utalhat, hogy a hálózatban utószaporodás történt, amit előidézhet:
- csővezetékek korróziója
- pangó víz a ritkán használt szakaszokon
- nagy szervesanyag-tartalom a nyersvízben
3. 37 °C-on tenyésztett telepszám
A 37 °C-on tenyésztett baktériumok közelebb állnak az emberi testhőmérséklethez, így ez a paraméter inkább az emberi eredetű szennyeződések (pl. szennyvíz-bejutás, higiéniai problémák) jelzője. Bár a legtöbb esetben itt sem kórokozó baktériumokat találnak, a megnövekedett érték arra figyelmeztet, hogy a vízben mikrobiológiai növekedést támogató körülmények jöttek létre.
4. Értelmezés és teendők
A telepszám növekedése esetén szükséges:
- a hiba okának feltárása
- a hálózat tisztítására vagy fertőtlenítésére
5. Összefoglalva
A 22 °C-on és 37 °C-on mért telepszám indikátor paraméter, amely segít felmérni, mennyire támogatja a vízrendszer a baktériumok növekedését. Bár önmagában nem jelent egészségügyi kockázatot, változásai fontos jelzések a vízhálózat karbantartásának és higiéniai állapotának megítéléséhez.